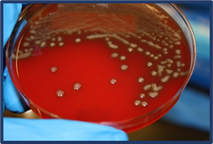
Plate

Research Activites

Besides working as a diagnostic laboratory of the Sahlgrenska University Hospital Department of Clinical Microbiology and maintaining one of the largest collections of pathogenic and other clinically-relevant bacteria, the CCUG is also active as a research unit, within the Sahlgrenska Academy in the Department of Infectious Diseases,
Institute of Biomedicine at the University of Gothenburg,
taking advantage of its extensive microbiological holdings. The CCUG Research Group is a multidisciplinary group with expertise in, systematic analyses, genomics, proteomics, molecular biology and bioinformatics, which allows CCUG to participate in national and international projects, with a respected reputation and a well-stablished and diverse worldwide research network.
taking advantage of its extensive microbiological holdings. The CCUG Research Group is a multidisciplinary group with expertise in, systematic analyses, genomics, proteomics, molecular biology and bioinformatics, which allows CCUG to participate in national and international projects, with a respected reputation and a well-stablished and diverse worldwide research network.
The research topics of the CCUG Research Group have
 been focused mainly on improving clinical diagnostics of infectious disease, including the detection and identification of virulence and antimicrobial resistance (AMR). During the last ten years, the CCUG Research group has been actively involved also in genome sequencing projects involving different Next-generation sequencing platforms (Illumina, PacBio and Nanopore sequencing), for genomic characterizations,
database curation, description of new species or solving taxonomical problems, as well as projects focused on better understanding of antibiotic resistance mechanisms. The CCUG Research team has also organized talks and teaching courses for students and other researchers. The CCUG has access to state-of-the-art facilities and equipment within the Department of Clinical Microbiology, Sahlgrenska University Hospital and through affiliation in the Sahlgrenska Academy of the University of Gothenburg.
been focused mainly on improving clinical diagnostics of infectious disease, including the detection and identification of virulence and antimicrobial resistance (AMR). During the last ten years, the CCUG Research group has been actively involved also in genome sequencing projects involving different Next-generation sequencing platforms (Illumina, PacBio and Nanopore sequencing), for genomic characterizations,
database curation, description of new species or solving taxonomical problems, as well as projects focused on better understanding of antibiotic resistance mechanisms. The CCUG Research team has also organized talks and teaching courses for students and other researchers. The CCUG has access to state-of-the-art facilities and equipment within the Department of Clinical Microbiology, Sahlgrenska University Hospital and through affiliation in the Sahlgrenska Academy of the University of Gothenburg.
The CCUG Research Group participates as Main Applicant (Principal Investigator)
 and Co-Applicant for regional, Västra Gotalandsregionen (www.fou.nu/is/alfgbg/ ) and national,
Vetenskapsrådet (www.vr.se/ ),
Formas (www.formas.se/en/ ), and
SIDA (www.sida.se/ ) projects. The CCUG has been active in international research projects, as participants in consortia supported by the European Commission Framework Programme and the European Science Foundation (ESF), as well as Co-Applicants in nationally-funded projects, e.g., from Spain, Chile, Belgium, Norway, Portugal, U.K., U.S.A., etc. Post-graduate students working on Masters (MS) and Doctoral (PhD) projects and Post-doctoral projects make the CCUG an active research collection.
and Co-Applicant for regional, Västra Gotalandsregionen (www.fou.nu/is/alfgbg/ ) and national,
Vetenskapsrådet (www.vr.se/ ),
Formas (www.formas.se/en/ ), and
SIDA (www.sida.se/ ) projects. The CCUG has been active in international research projects, as participants in consortia supported by the European Commission Framework Programme and the European Science Foundation (ESF), as well as Co-Applicants in nationally-funded projects, e.g., from Spain, Chile, Belgium, Norway, Portugal, U.K., U.S.A., etc. Post-graduate students working on Masters (MS) and Doctoral (PhD) projects and Post-doctoral projects make the CCUG an active research collection.